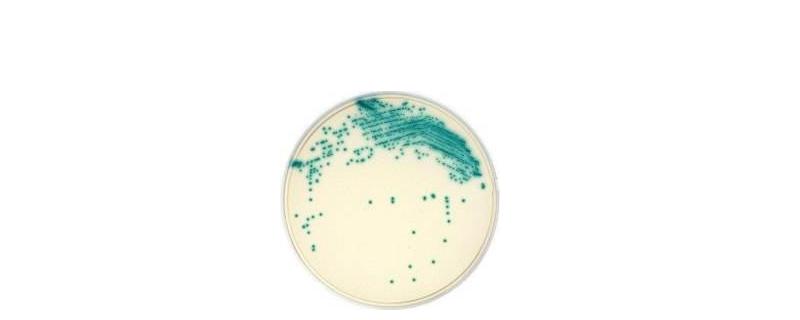
微生物培养基质有哪些种类，成分一般包括什么

微生物菌剂的使用方法和禁忌
作者:李宗全
2020-06-03 12:42:31

使用方法:作为底肥和追肥使用时可以直接将其撒入土中,然后再覆盖一层土壤即可;作种肥使用时可在播种前用适量的菌剂与种子混匀,然后按照常规的育苗方式或播种方法进行播种即可。使用禁忌:使用微生物菌剂时要注意避免和杀菌剂、杀虫剂等药物混用;忌在光照较强的时候使用微生物菌剂;忌微生物菌剂过期后仍然继续使用。
- 问微生物接种技术有哪些平板划线接种是将细菌分离培养的常用技术,目的是使混有多种细菌的培养物形成单个菌落或分离出单一菌株,以便于识别和鉴定;斜面接种主要用于移种纯菌,使其增殖后用于鉴定或保存菌种;注射接种即用注射的方法将待接的微生物转接至活的生物体内,如人或其它动物中。
- 问微生物的产能方式有哪些微生物的产能方式主要有呼吸、无机物氧化、发酵、光合磷酸化。微生物包括细菌、病毒、真菌以及一些小型的原生生物、显微藻类等生物在内的一大类生物群体,它的体型虽然比较微小,但是与人类的关系非常密切。
- 问微生物的作用有哪些拮抗作用:微生物通过拮抗作用,抑制并排斥过路菌群的入侵和群集,从而调整了人体与微生物之间的平衡状态。分解作用:土壤中含有较多的有机质,微生物能够将其分解使土壤变得肥沃,同时它还能分泌出多种酶和生长刺激素,从而促进植物或农作物的生长。
- 问微生物接种的方法,接种环直径是多少微生物接种指的是将微生物移动到适合它生长繁殖的培养基上,常见的微生物接种方法包括:划线接种、三点接种、穿刺接种、浇混接种、涂布接种、液体接种、注射接种以及活体接种这8种。
三农问答